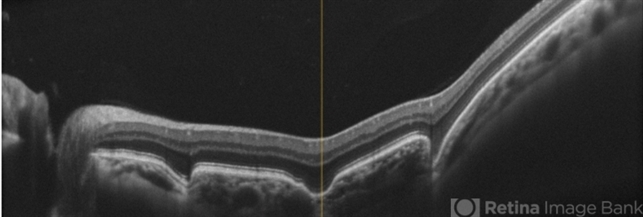

File number: 28774
Comments
-
Nelson Chamma Capelanes, MD (January 11 2019)
Very nice image!
Sign in to comment.
-
By Aristofanes Canamary jr
Paulista’s Ophthalmology Unity
Co-author(s): Nelson Capelanes, Caio Regatieri - Uploaded on Jan 6, 2019.
- Last modified by Caroline Bozell on Jan 8, 2019.
- Rating
- Appears in
- 6-Jan-2019
- Condition/keywords
- optical coherence tomography (OCT), excavation, pachychoroid
- Photographer
- Aristófanes Canamary Jr, UPO ophthalmology, Sao Paulo
- Imaging device
- Optical coherence tomography system
- Description
- A 51-year-old female who reported low visual acuity on AO, worse in the OE. Fundoscopy of OE is observed color and brightness alteration in macular region. Focal concave-shaped chorioretinal anomaly in the foveal region and other two anomaly peripapilary and temporal to the fovea with a hyporreflective subretinal space distinguishing from each other.